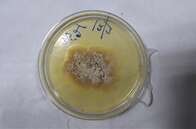
Indiano se torna a primeira pessoa da história a ser infectada por um fungo até então exclusivo de plantas

Celebridades
Cantor Nico Fidenco, do sucesso Legata a un Granello di Sabbia, morre aos 89 anos
O artista italiano ganhou visibilidade internacional com a música lançada em 1961

O cantor e compositor Nico Fidenco morreu na madrugada deste sábado (19/11) em Roma, aos 89 anos. A notícia foi pela esposa Annamaria e a filha Guendalina, segundo o jornal italiano La Reppublica. Na década de 1960, o artista ficou famoso com canções de amor como Legata a un Granello di Sabbia e Con Te Sulla Spiaggia.
Aliás, o sucesso Legata a un Granello di Sabbia chegou a ser rejeitado no tradicional Festival de Sanremo de 1961, mas quando foi lançado como single ultrapassou um milhão de cópias vendidas. Foi um dos primeiros hits de Verão na história da música italiana, revela o jornal.
Nico Fidenco foi o pseudônimo escolhido por Domenico Colarossi, que nasceu em Roma em 24 de janeiro de 1933, mas depois viveu com a família em Asmara, na Eritreia, até os 16 anos. Aos 27, já fazia parte da gravadora italiana RCA. O primeiro sucesso foi uma música usada como trilha sonora do filme I Delfini de Citto Maselli: What a Sky, composta pelo maestro Giovanni Fusco. Que devido ao sucesso do filme também foi lançado como single em italiano com o título Su Nel Cielo que, em 31 de dezembro de 1960, permaneceu quatro semanas no topo da parada de sucessos.
Para se ter uma ideia do sucesso de Legata a un Granello di Sabbia, ela permaneceu em primeiro lugar por 14 semanas. Em 1964, a canção Con Te Sulla Spiaggia ocupou a segunda posição na parada de sucesso. Como mostra o La Reppublica, o sucesso de Nico Fidenco caiu na segunda metade da década de 1960, apesar de sua primeira e única participação no Festival de Sanremo, em 1967.
Entre o final dos anos 70 e 80, o músico italiano viu um novo “boom” na carreira, graças às canções-tema de alguns desenhos animados japoneses como Hela Supergirl e Cyborg.
De 1984 a 1994, com os colegas Riccardo Del Turco, Jimmy Fontana e Gianni Meccia, deu vida ao quarteto chamado I Super 4, que apresentava sucessos dos repertórios dos anos 60 respectivos membros, mas todos rearranjados em tom moderno. Foram lançados três álbuns de sucesso moderado.